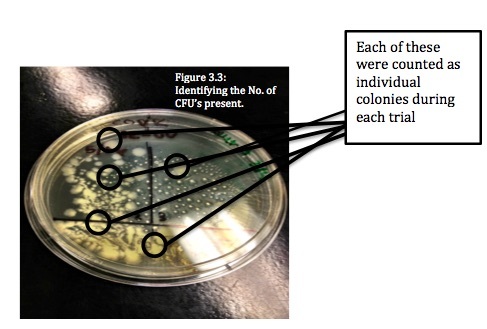
The Effects of Ultraviolet Light on <em>Escherichia coli</em>

In this article, the authors compare different resource-efficient farming methods for the vegetable Lactuca sativa. They compared hydroponics (solid growth medium with added nutrients) to aquaponics (water with fish waste to provide nutrients) and determined efficacy by measuring plant height over time. While both systems supported plant growth, the authors concluded that aquaponics was the superior method for supporting Lactuca sativa growth. These findings are of great relevance as we continue to find the most sustainable and efficient means for farming.
Read More...